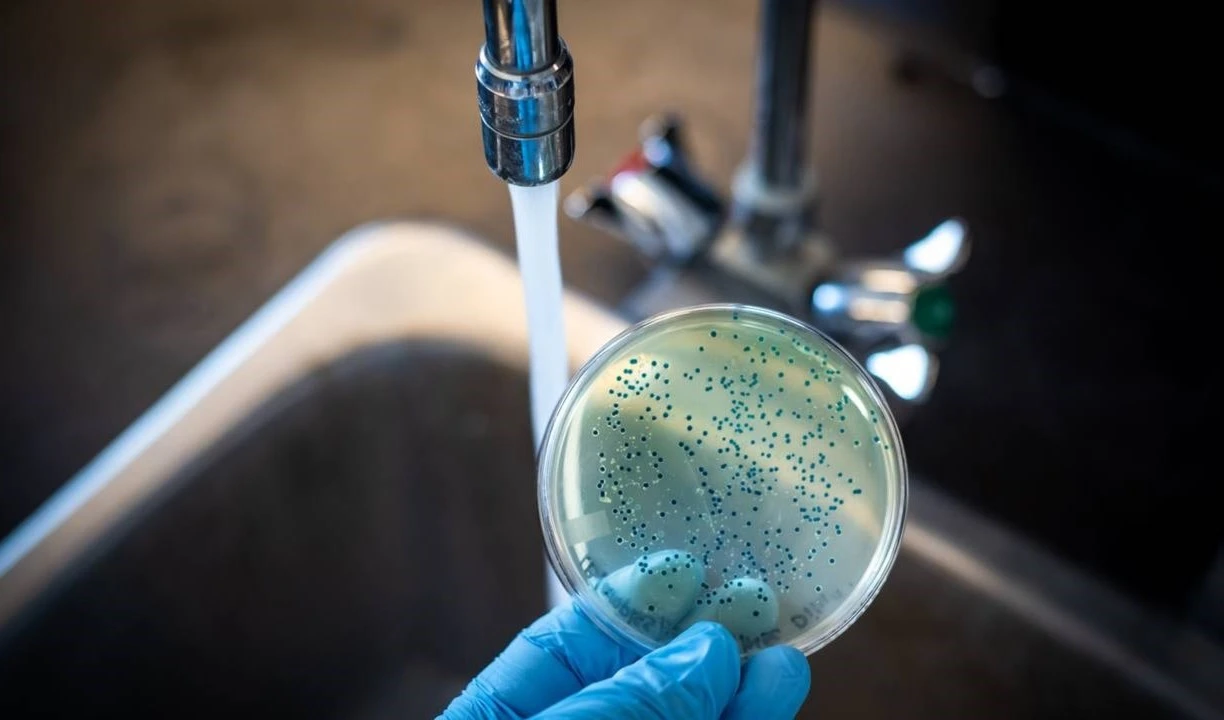
Agua contaminada. Imagen ilustrativa: Redes.

Aumentan casos confirmados de cólera en Haití
Desde el 1 de octubre de 2022, cuando se confirmó el primer caso de cólera en Puerto Príncipe, la epidemia se extendió rápidamente por todo el país.
-

Las autoridades de salud resaltan la incidencia del virus en las edades más tempranas.
La Oficina para la Coordinación de Asuntos Humanitarios (OCHA, por sus siglas en inglés) alertó sobre la propagación de los casos sospechosos de cólera en Haití y el necesario apoyo de las organizaciones humanitarias para contener el brote.
El Ministerio de la Salud Pública y Población del país caribeño informó sobre 18 mil 799 casos sospechosos, mil 380 confirmados, 16 mil 47 hospitalizados y 342 fallecidos.
Hasta el 22 de diciembre se analizaron tres mil 558 muestras recibidas con una tasa de positividad del 38,78 por ciento.
Del total de casos, 57,84 por ciento corresponden al sexo masculino y 42,16 al femenino.
El ente gubernamental resaltó la preocupación por la incidencia del virus en las edades más tempranas. Existen un total de tres mil 592 enfermos de cólera entre uno y cuatro años, informaron las autoridades.
Las cifras de sospechosos prevalecen en comunidades como Saint – Marc, Carrefour, Cité -Soleil y Puerto Prínce, mientras que los confirmados colmaron las pesquisas en Mirebalais, Cité–Soleil, Delmas y la capital, resaltó el informe.
Desde el 1 de octubre de 2022, cuando se confirmó el primer caso de cólera en Puerto Príncipe, la epidemia se extendió rápidamente por todo el país.
Los actores humanitarios apoyan al gobierno haitiano para garantizar la creación y el funcionamiento de los centros de tratamiento, el suministro de insumos y la sensibilización de la población para limitar la propagación de la enfermedad, subrayó la agencia de Naciones Unidas.
El Gobierno de Haití, la ONU y sus socios, solicitaron 145,6 millones de dólares para apoyar la respuesta de emergencia al brote y proporcionar asistencia vital a 1,4 millones de personas que viven en las zonas más afectadas.
Haití enfrentó una epidemia colérica en 2010 a raíz de un mortal terremoto que provocó la muerte a más de 200 mil personas y fueron necesarios nueve años para contener la enfermedad que cobró la vida de unas 10 mil víctimas.